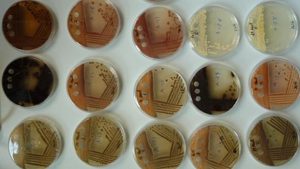

ترجمة: ابتهاج عباس احمد
احتمالية الحصول على مضادات حيوية للسرطان: من بكتريا ماء المطر
قام فريق من العلماء الاسبان من جامعة اوبيدو و جامعة استورياس بالتعاون مع جامعة تونجن الالمانية, باكتشاف بكتيريا موجودة في مياه الامطار, تعالج حلات خاصة من مرضى السرطان خاصة تلك التي تنتمي الى جنس المتسلسلة.
كما اوضح الباحث غلوريا بلانكو, بأن معظم المضادات الحيوية للاورام تأتي من الطبيعة.من تاتي اهمية المصدر الجديد لعزل البكتريا امام تزايد مقاومة الفايروس امام العقاقير التقليدية. و اوضحت البحث بلانكو ان العمل بعزل البكتريا جنس المتسلسلة بدءا من عام 2007من خلال نباتات ارضية (اشنه) و بعد ثلاث سنوات تم اكتشافها في عشب البحر في شواطئ خيخون او البيئات البحرية العميقة . قبل ذلك كانو يقومون بعزل البكتريا الشعاعية الموجودة في المطر و البرد و الثلج.
وجود الفطريات الشعاعية في المطر له قيمة بيئية مضاعفة, حيث يقول العلماء بان هذه البكتريا التي تصعد مع بخار المحيط الى السماء ثم تنزل الى مع الامطار حيث افترض العلماء وجود دائرة بيئية تتكون من خلالها هذه البكتريا .
ان النقطة الاساسية لتكوين هذه البكتريا هو رذاذ البحر و التي بدورها تشكل الغيوم. لقد نشرت هذه الابحاث مؤخرا في مجلة (علم البيئة الميكروبية). لقد واجه العلماء العديد من الصعوبات في دراسة المشروع و تمويله وقال الباحثون بأنهم يأملون بالحصول على الدعم المالي لتحليل السلالات المعزولة و المخزونة اكدت بلانكو بأنها يمكن ان تصل الى 1.000 سلالة وخصوصا تلك المأخوذة من محيط كانيون دي ابيلا . اما عن مستقبل أن الهدف الاساسي لها ولزملاءها هو اكتشاف التركيبة الجديدة و التي تتواجد في البيئة و توزيع الفطريات الاشعاعية في الطبيعة. كما تؤكد ان بعضها لاي نوع من السرطان يمكن ان تعالج . ان الهدف من هذه الابحاث هونقل المعرفة الى شركات الادوية ووضعه هناك كبراءة اختراع او للاعلان عنه.
http://www.abc.es/ciencia/abci-posible-fuente-nuevos-antibioticos-y-antitumorales-bacterias-agua-lluvia-201511132027_noticia.html